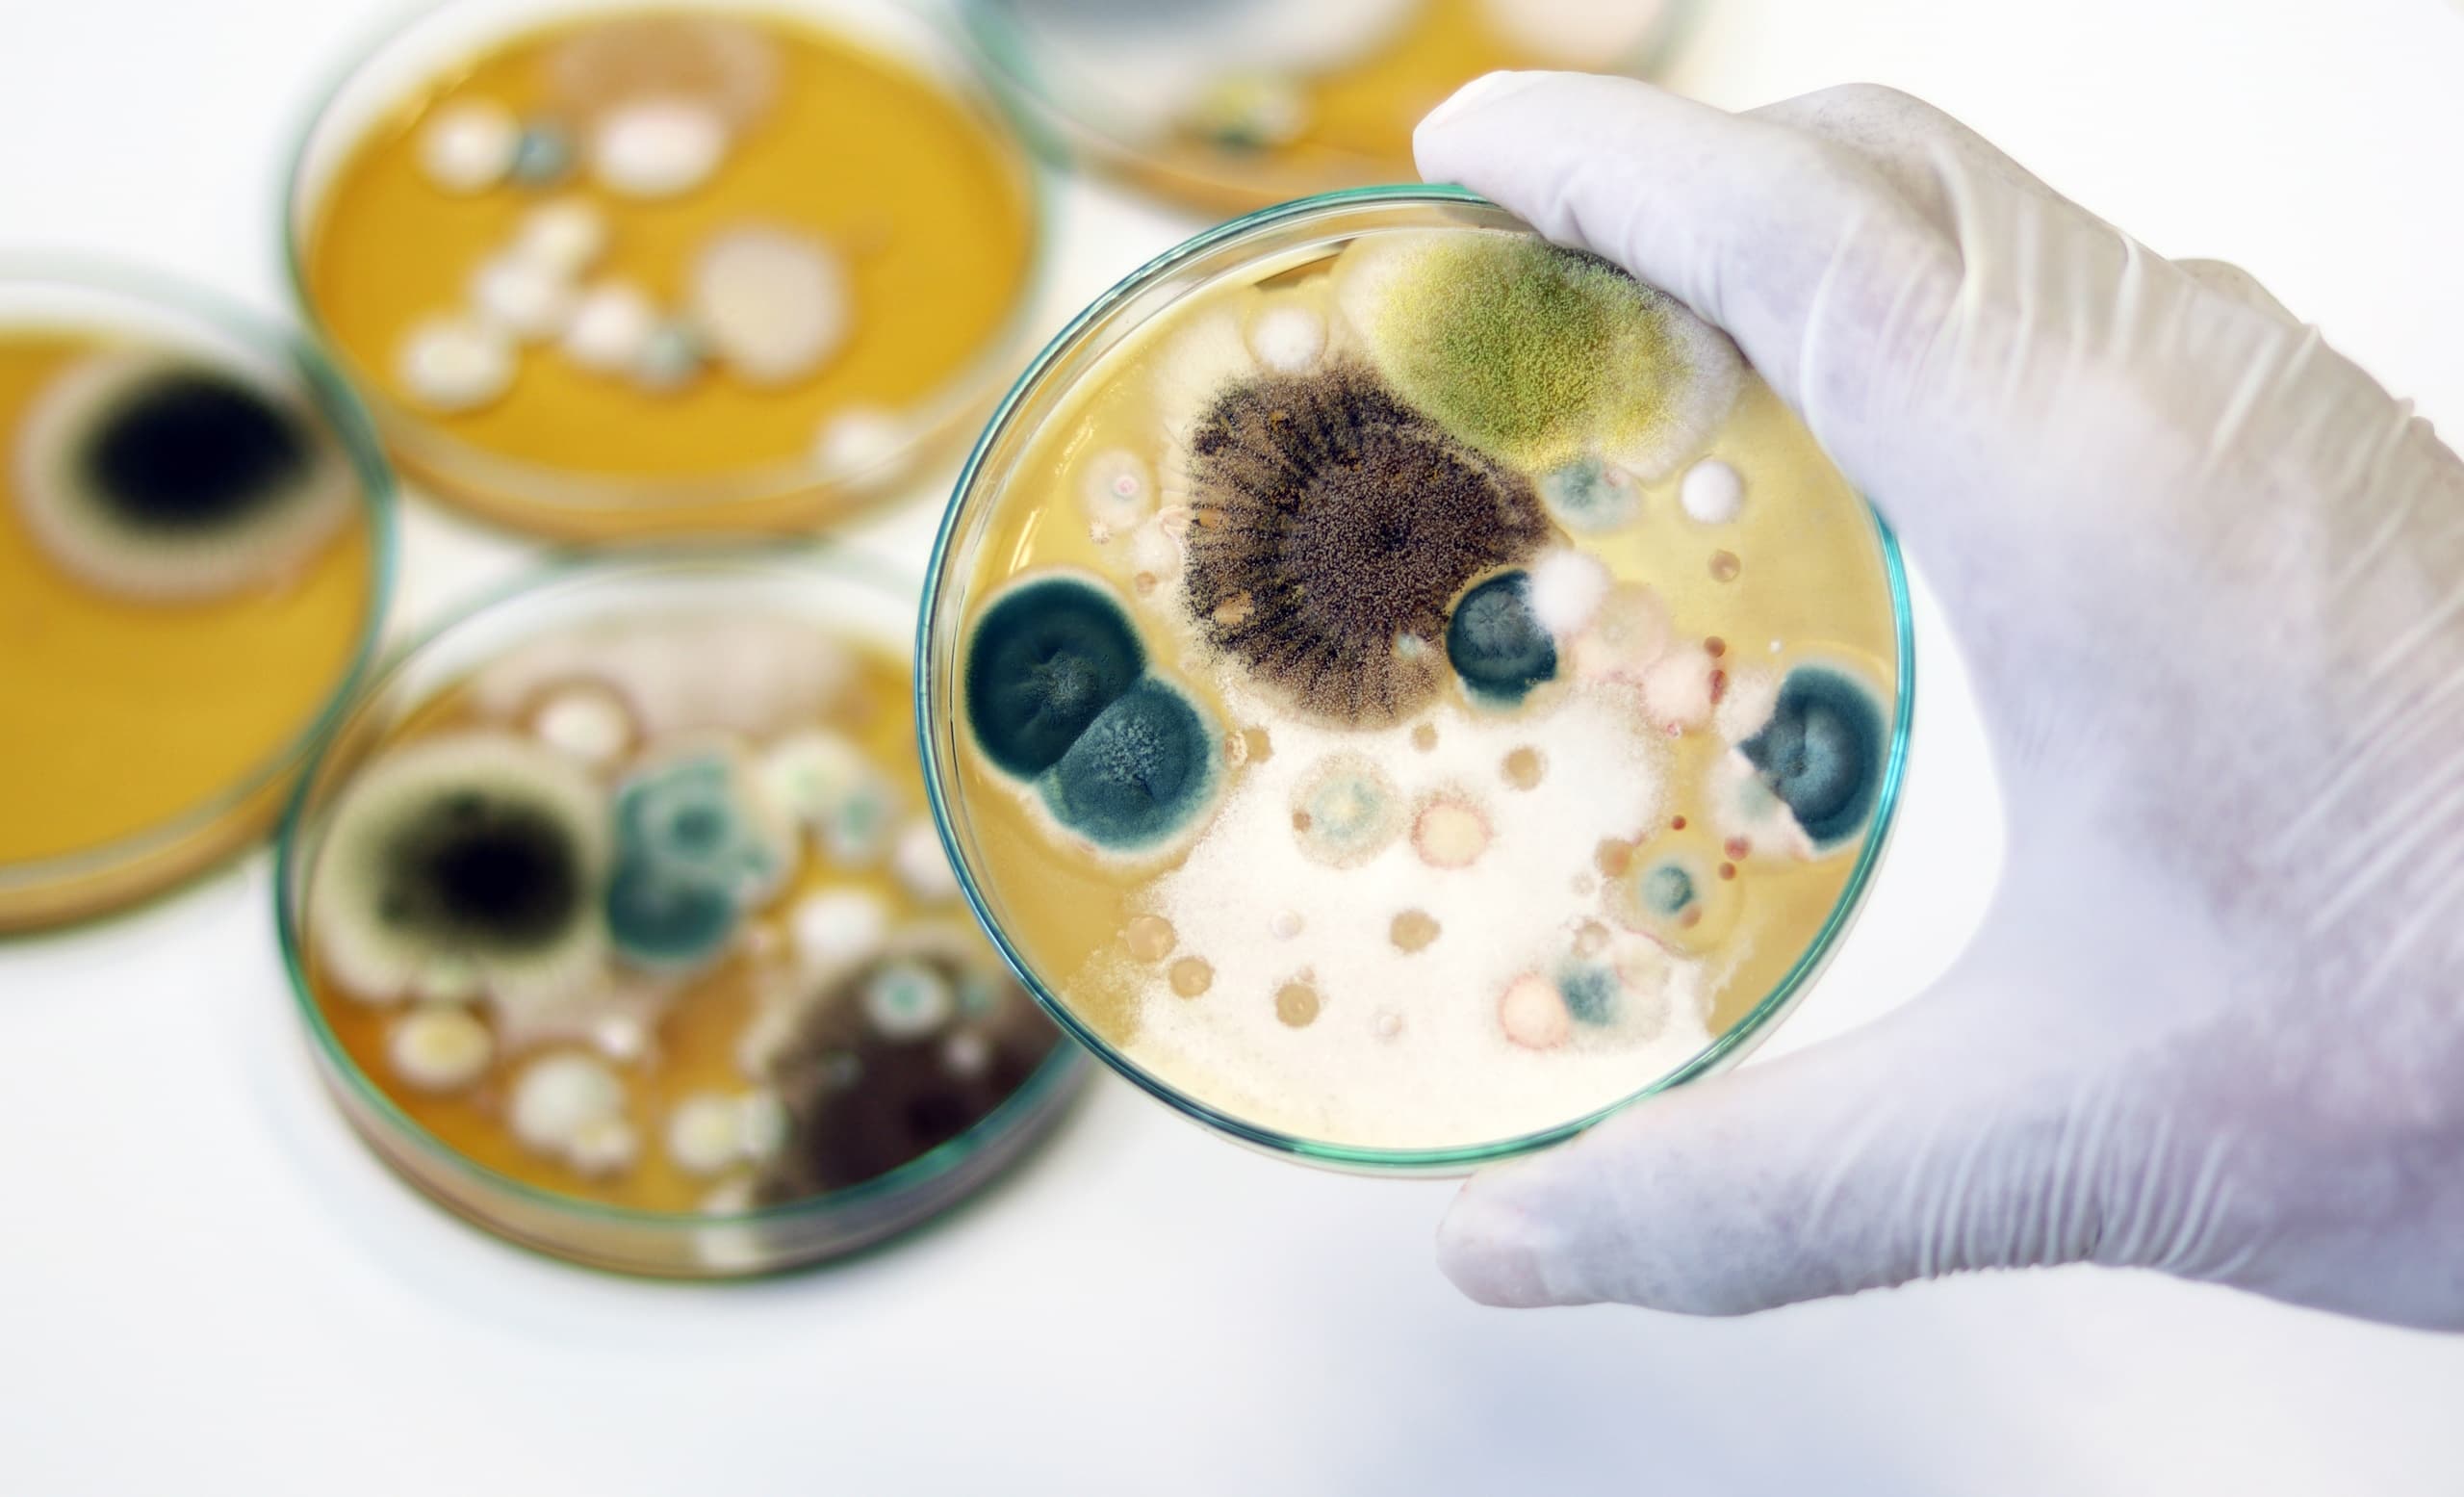
Mold Testing, Mold Removal, Mold Remediation, Black Mold, Disaster Blaster Mold Remediation

When you’re concerned that there might be a mold problem in your home, there are a lot of questions and concerns that likely go through your head. Do I really have a mold problem? If I do, how bad is it? How do I find out?
The fact of the matter is that mold issues can be confusing and most homeowners don’t know where to begin, which is why professional Mold Remediation firms such as Disaster Blaster are such an important part of the process. Not only do we demystify the process and answer a lot of the questions that you have, but we review mold test results (where appropriate) and formulate a plan to address the issue safely and effectively.
One of the most common questions we get is what the best mold test is, and where mold testing should be performed. Here are some tips from 30 years in the mold remediation industry!
Mold Test Kits / Mold Petri Dish Kits
The home test kits for mold that are sold in many stores contain a collection surface (generally a petri dish) and a growth medium. These test kits are NOT intended to provide you with any detailed information about the mold strains that grow in the culture or the severity of a mold issue in an area.
What are Mold Test Kits good for? Mold Test Kits will show you what mold growth COULD develop in a space given the ideal conditions and based on the mold spores in the air during your test period.
What are the limitations of Mold Test Kits? While interesting as a curiosity, mold test kits are the most inaccurate test you could perform and are not a representation of an actual mold issue that may exist in your home. Since mold test kits use a growth medium to collect mold spores in the petri dish, and mold spores exist in every environment naturally, mold test kits will always show a worst case scenario. Mold Test Kits will collect dormant, and even transitory, mold spores that otherwise would not result in any mold growth inside your home and provide them with the perfect environment to grow, making an issue appear far worse than it may be.
Who can perform a Mold Test with a Mold Test Kit? Homeowners can perform a mold test with a mold test kit, and because mold test kits provide no details that need to be reviewed or interpreted, an expert is not necessary to review the mold test kit results.
Mold Swab Tests / Mold Strip Tests
Mold swab tests and Mold strip tests take an isolated sample that is then cultured to determine what was present in that sample. More commonly used to determine what mold spores may be present in a space than the potential extent of mold issues, Mold swab tests and mold strip tests are rarely, if ever, used as part of the design or completion of a mold remediation project.
What are Mold Swab Tests / Mold Strip Tests good for? Similar to mold test kits (above), mold swab tests and mold strip tests do culture the sample, providing otherwise dormant mold spores an opportunity to grow. As mold swab tests and mold strip tests are able to tell you the mold strains in a given area (where you swabbed), they can be useful in identifying what particular strains may be causing allergic reactions or health issues.
What are the limitations of Mold Swab Tests / Mold Strip Tests? Due to the fact that mold swab tests and mold strip tests are a collection of dust, debris, and mold spores that have settled on a surface over an unknown period of time, they are not useful or intended for use in determining the extent of a mold issue in a property or designing a mold remediation project.
Who can perform a Mold Swab Test / Mold Strip Test? Some home test kits are available and mold swab testing / mold strip testing is also available from some mold testers. It’s important to work with mold testers that understand the purpose of different mold testing methods and that make recommendations based on your needs.
Mold Air Sample Testing
The industry standard for determining if, and to what extent, a mold issue may exist in a property, Mold Air Sample Testing uses a vacuum to suck air into a collection canister, where it is then sent to a lab for detailed analysis. Unlike other methods mentioned above that provide very limited results (if any), the laboratory reports provided for mold air sample testing include detailed spore counts and a comparison to presumed unaffected or outdoor testing measurements. As a result, mold air sample testing provides a tremendous amount of detail that Mold Remediation Professionals are able to use to determine the scope of any contamination and to develop a plan to address issues effectively.
What are Mold Air Sample Tests good for? Because mold air sample tests provide so much detail, they are ideal for identifying mold issues inside properties, determining the scope of any known contamination, and development of a remediation plan to address the issue. Mold air sample tests can also be used to determine the likelihood of mold growth in areas we can’t see, such as inside wall cavities, under floors, or above ceilings. Due to the versatility of mold air sample testing, they are also much better at identifying potential causes of health issues or allergic reactions.
What are the limitations of Mold Air Sample Testing? Similar to any other mold test, mold air sample testing is only a snapshot of the conditions at the time of the test and doesn’t show past or future issues. With that said, Mold Air Sample Testing is by far the best method of testing for mold problems and the standard for identifying indoor mold issues.
Who can perform Mold Air Sample Testing? A qualified Mold Tester is needed to perform mold air sample testing, as they will need specialized equipment to collect the sample and relationships with laboratory facilities to analyze it and prepare the report. Once the mold air sample testing report has been prepared, the Mold Tester and Mold Remediation Firm should review the results and develop a plan to address any issues that may potentially exist.
How do you select a Mold Tester?
It can be stressful whenever you’re hiring someone to test for something that you can’t see. Here are a few tips for picking the right Mold Tester for your needs:
- Mold Testers should NOT provide Mold Remediation Services as well. This is a conflict of interest.
- Mold Testers should be able to perform a variety of mold testing services, particularly Mold Air Sample Testing.
- Mold Testers should be able to make recommendations of where test samples should be taken and recognize areas of your property that may be of concern.
- Mold Testers should have a clear understanding of the test results and be able to review these with you and answer your questions.
Where should you Test for Mold?
One of the most common misunderstandings about mold testing is where you should have it performed. Often a homeowner may see a potential mold issue and set up a mold test (or have qualified mold testing performed) right near it, but that’s often a waste of money…
Instead, mold testing should be used to determine the scope of the mold contamination (where the contamination ends). This allows a qualified mold remediation firm like Disaster Blaster to isolate clean areas and design a project that meets the unique needs of your property and the mold issue that may exist. Here are some areas that you may want to have tested and why:
- When there is a belief that a mold issue may exist but no visible indications of a mold issue, mold air testing can identify potential mold growth inside wall cavities, above ceilings, or below floors.
- When mold is discovered in a room, testing adjoining rooms is often recommended to determine the scope of the mold contamination and what rooms are “clean”.
- In cases where leaks have occurred, it may be recommended to test for mold in rooms above or below an area that is known to be contaminated.
How do you understand Mold Testing Results?
Unlike other tests, Mold Testing isn’t a clear “good” or “bad” result as average mold counts can vary drastically from one place to another. Instead, mold testing is a comparative result, which means that a baseline sample is taken (generally outside the property or in a known unaffected area) and the mold test results are compared to that baseline sample.
It’s important to keep in mind that each mold strain should be compared independently, so as you read through the Mold Testing Results, you will want to compare each result to the accompanying result in the baseline. Results that are higher than the baseline are generally viewed as indicating a mold contamination issue that should be rectified.
When having mold testing performed, both the Mold Tester and your local Disaster Blaster should be more than happy to review the results with you, answer any questions that you may have, and detail recommendations that may be necessary to address the mold issue.
We hope that this information was helpful and answers some common questions you may have about the mold testing process. As always, should you suspect you have a mold issue, or have any questions about mold problems, please don’t hesitate to Contact Your Local Disaster Blaster for an evaluation. We’re always here to help!
Interested in older news stories? Please see our News Archive.